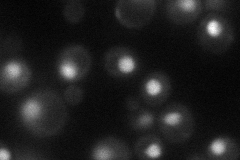
YGL133W
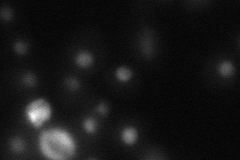
YGL133W
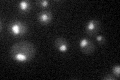
YGL133W

View description
Component of the ATP-dependent Isw2p-Itc1p chromatin remodeling complex, required for repression of a-specific genes, repression of early meiotic genes during mitotic growth, and repression of INO1
Localization:
Intensity:
Fold change:
Significance:
-
C’ GFP library in SD

nucleus31.31 -
N' NOP1pr-GFP in SD
nucleus49.6811 -
N' TEF2pr-mCherry in SD
nucleus65.88 -
N' NATIVEpr-GFP in SD

missing0 -
N' TEF2pr-VC and Cyto-VN in SD

#N/A0 -
C’ GFP library in SD+DTT

nucleus27.550.88No -
C’ GFP library in SD+H2O2

nucleus38.991.24No -
C’ GFP library in Starvation Media
nucleus31.270.99No -
C’ GFP library on the background of Pup2-DaMP

nucleus -
C’ GFP library on the background of CCT mutant

nucleus35.75241.14171No
